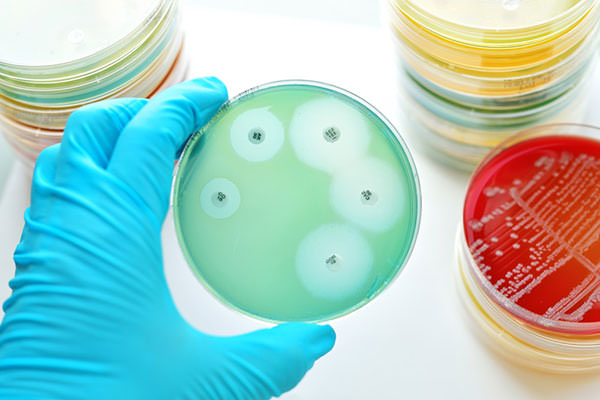
product details

Hospital Acquired Infections
Hospital-Acquired or nosocomial infections (HAI) are infections acquired during hospital care that are not present or incubating at admission to the hospital.

Transmission and impact
Surronding each patient
Transmitted from patient to patient or contaminated equipment and surfaces, HAI include catheter-associated urinary tract infections, bloodstream & surgical site infections, pneumonia, and Clostridium difficile. By prolonging patients hospitalization and worsening patients’ outcomes, the economic burden of nosocomial diseases is considerable.
HAI & Antimicrobial resistance
An endemic issue
As antimicrobial agents became widely used, resistant bacteria emerged and spread in the healthcare setting. As a result, antimicrobial agents became, in some cases, less effective and many resistant strains – such as Legionella, Staphylococcus aureus, Multiresistant Klebsiella, and Pseudomonas aeruginosa – became endemic in hospitals.
Detect the invisible!
Most HAI pathogens can survive on dry surfaces for extended periods and are challenging to eradicate by cleaning and disinfection. Our HAI-related products are the best option to detect these microorganisms, both in patients and on your hospital equipment.

eSwab®
Multipurpose collection and transport system

FecalSwab™
Collection, transport & preservation system for enteric pathogens
Are you looking for something in particular?
We offer many products that differ in features, design, and compatibility. To find the best one for your needs, use our search tool combining keywords such as application, collection site, microorganism, diagnostic assay… and so on!
Let's Connect
Have questions or ideas? Reach out and let's start a meaningful conversation.
Get in TouchAdvancing Diagnostics in India
Advancing Diagnostics in India through Global Innovation and Local Expertise.
Know More







